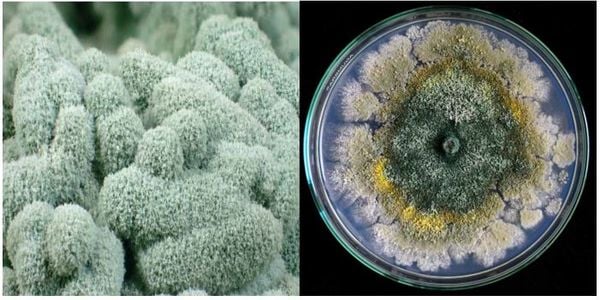

Nấm Trichoderma loại nào tốt - Tìm hiểu về các loại nấm Trichoderma tốt nhất
Nấm Trichoderma là một loại nấm có tính chất rất đặc biệt và được sử dụng trong nhiều lĩnh vực, đặc biệt là trong nông nghiệp. Với khả năng giúp cải thiện chất đất, bảo vệ cây trồng khỏi các bệnh hại và kích thích sự phát triển của cây, nấm Trichoderma đã trở thành một lựa chọn tuyệt vời cho các nhà nông và người trồng cây. Tuy nhiên, trên thị trường hiện nay có rất nhiều loại, vậy Nấm Trichoderma loại nào tốt? Hãy cùng SenAgri.vn tìm hiểu về các loại nấm Trichoderma tốt nhất trong bài viết này.
1. Lợi ích của việc sử dụng nấm Trichoderma trong nông nghiệp
Việc sử dụng nấm Trichoderma trong nông nghiệp không chỉ mang lại hiệu quả cao trong việc bảo vệ cây trồng và cải thiện chất đất, mà còn có nhiều lợi ích khác như sau:

1.1 Bảo vệ môi trường
Nấm Trichoderma là một loại vi sinh vật tự nhiên, không gây hại cho môi trường và con người. Việc sử dụng nấm Trichoderma thay thế cho các loại thuốc trừ sâu và phân bón hóa học sẽ giúp giảm thiểu ô nhiễm môi trường và bảo vệ sức khỏe của con người.
1.2 Tăng năng suất và chất lượng sản phẩm
Nhờ vào khả năng cải thiện chất đất và bảo vệ cây trồng, việc sử dụng nấm Trichoderma sẽ giúp tăng năng suất và chất lượng sản phẩm. Các cây trồng được bảo vệ bởi nấm Trichoderma sẽ phát triển khỏe mạnh hơn, cho ra nhiều quả và có chất lượng tốt hơn.
1.3 Tiết kiệm chi phí
Việc sử dụng nấm Trichoderma sẽ giúp tiết kiệm chi phí cho việc mua thuốc trừ sâu và phân bón hóa học. Đồng thời, do nấm Trichoderma có tính chất tự nhiên và không gây hại cho môi trường, nên sẽ giúp giảm thiểu chi phí cho việc xử lý ô nhiễm môi trường.

Xem thêm: Các loại chất hữu cơ tốt cho cây
2. Những lưu ý khi sử dụng nấm Trichoderma để đạt hiệu quả cao nhất
Để đạt được hiệu quả tốt nhất khi sử dụng nấm Trichoderma, chúng ta cần lưu ý một số điều sau:
2.1 Chọn loại nấm Trichoderma phù hợp
Trên thị trường hiện nay có rất nhiều loại nấm Trichoderma khác nhau, vì vậy chúng ta cần chọn loại nấm phù hợp với cây trồng và điều kiện đất đai của vùng trồng. Nếu không chọn đúng loại nấm, có thể sẽ không đạt được hiệu quả mong muốn hoặc thậm chí gây hại cho cây trồng.
2.2 Sử dụng đúng liều lượng và cách thức áp dụng
Việc sử dụng đúng liều lượng và cách thức áp dụng là rất quan trọng để đạt hiệu quả cao khi sử dụng nấm Trichoderma. Thông thường, nấm Trichoderma sẽ được bán dưới dạng bột hoặc hạt, và cần được pha loãng với nước trước khi sử dụng. Chúng ta cần tuân thủ đúng hướng dẫn của nhà sản xuất để đảm bảo hiệu quả tối đa.
2.3 Bảo quản đúng cách
Nấm Trichoderma là một loại vi sinh vật sống, vì vậy cần được bảo quản đúng cách để đảm bảo tính hiệu quả của nó. Nấm Trichoderma cần được bảo quản ở nhiệt độ và độ ẩm thích hợp, tránh ánh nắng trực tiếp và các tác nhân gây hại khác.

3. Khám phá những ứng dụng đa dạng của nấm Trichoderma trong nông nghiệp
Nấm Trichoderma không chỉ có tác dụng trong việc bảo vệ cây trồng và cải thiện chất đất, mà còn có rất nhiều ứng dụng khác trong nông nghiệp.
3.1 Sử dụng trong sản xuất phân bón hữu cơ
Nấm Trichoderma là một nguồn cung cấp dinh dưỡng tự nhiên cho cây trồng, vì vậy có thể được sử dụng trong sản xuất phân bón hữu cơ. Nấm Trichoderma sẽ giúp tăng cường hoạt động của vi sinh vật có lợi trong phân bón và cải thiện chất đất, giúp cây trồng phát triển khỏe mạnh.
3.2 Sử dụng trong sản xuất thuốc trừ sâu tự nhiên
Nấm Trichoderma cũng có thể được sử dụng để sản xuất các loại thuốc trừ sâu tự nhiên. Các chất kháng sinh tự nhiên có trong nấm Trichoderma sẽ giúp ngăn chặn sự phát triển của các loại vi khuẩn gây hại cho cây trồng, giúp bảo vệ cây trồng một cách hiệu quả và an toàn.
3.3 Sử dụng trong chế biến thực phẩm
Nấm Trichoderma còn có thể được sử dụng trong chế biến thực phẩm như là một chất chống oxi hóa tự nhiên. Các chất chống oxi hóa có trong nấm Trichoderma sẽ giúp bảo quản thực phẩm lâu hơn và giữ được hương vị tươi ngon.
Xem thêm: Phân bón nào tốt cho cây?
4. Kết luận
Trên đây là Nấm Trichoderma loại nào tốt? chúng ta có thể thấy rõ rằng nấm Trichoderma là một loại nấm có tính chất đặc biệt và có nhiều lợi ích trong nông nghiệp. Tuy nhiên, để đạt được hiệu quả tốt nhất khi sử dụng nấm Trichoderma, chúng ta cần chọn loại nấm phù hợp, tuân thủ đúng liều lượng và cách thức áp dụng, cũng như bảo quản đúng cách.